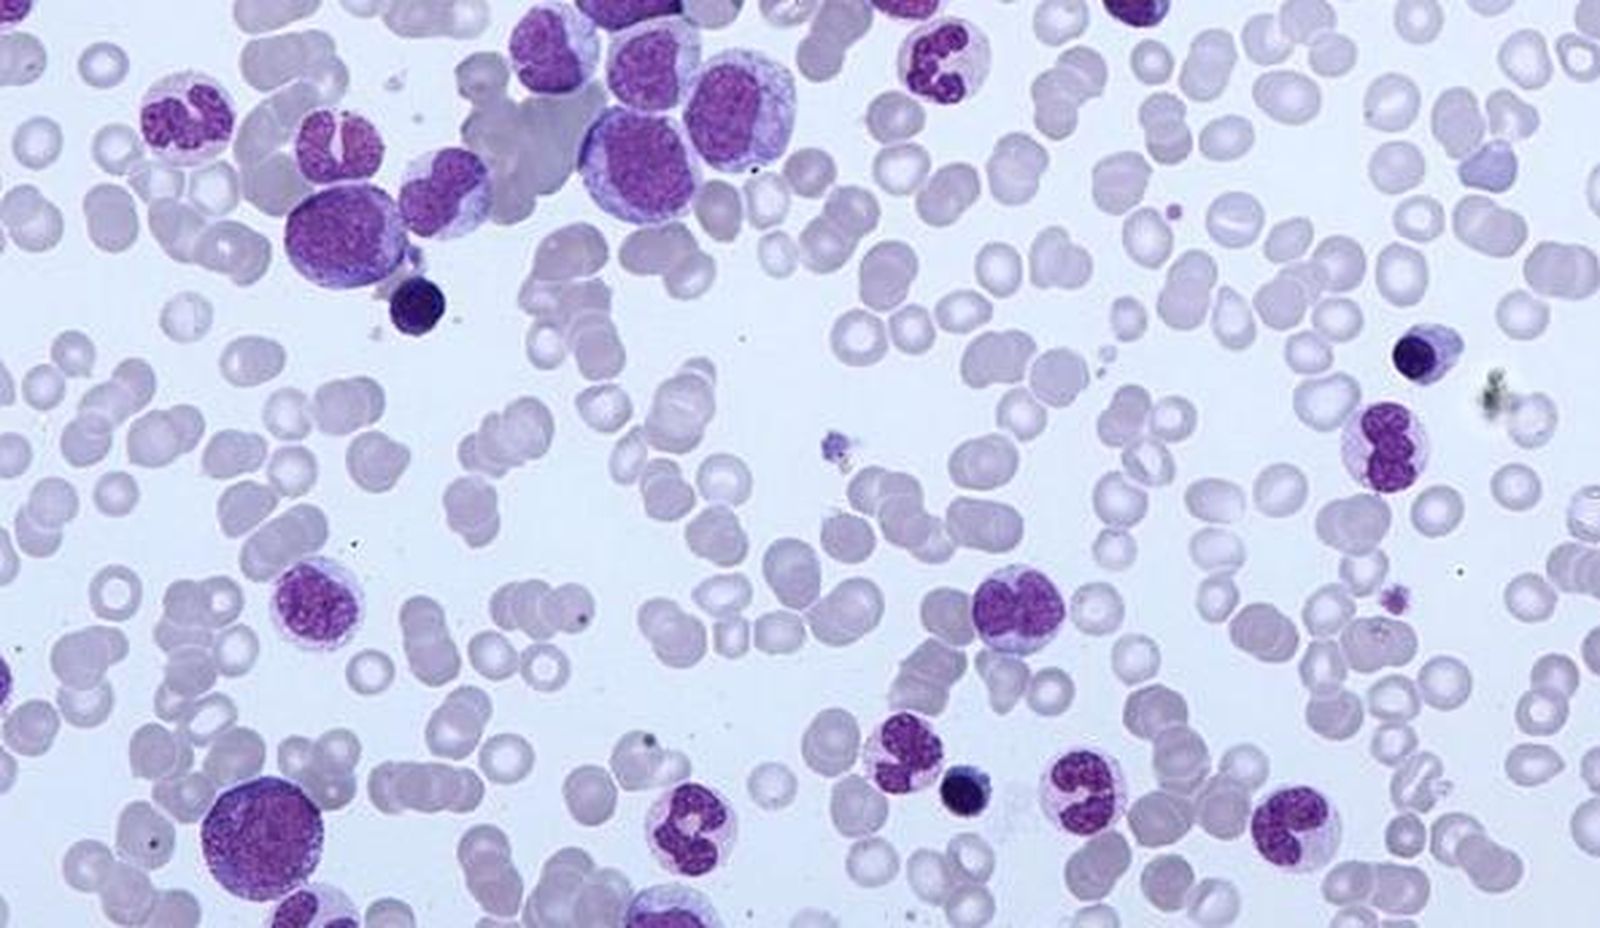
Investigadores hallan una estrategia no tóxica para tratar la leucemia

Generan un modelo de ratón que permitirá estudiar la progresión de un tipo de leucemia y buscar nuevos tratamientos
El grupo de investigación ha presentado todos los detalles de este nuevo modelo único en la revista científica 'Leukemia'.
Un equipo de Clínic-IDIBAPS, en colaboración con el Centro de Investigación Biomédica en Red de Cáncer (CIBERONC), ha generado un modelo de ratón que permitirá estudiar la progresión de un tipo de leucemia y buscar tratamientos más efectivos para los pacientes, que actualmente tienen pocas opciones terapéuticas.
La leucemia linfática crónica se caracteriza por la proliferación de células B del sistema inmune. Aunque generalmente es un tipo de leucemia indolente, entre el 5 y el 10 por ciento de los pacientes terminan desarrollando un linfoma más agresivo y con peor pronóstico. Este proceso se llama la transformación de Richter.
El grupo de investigación ha presentado todos los detalles de este nuevo modelo único en la revista científica 'Leukemia'. Para generar el modelo, el grupo de investigación en Terapias experimentales en neoplasias linfoides del Clínic-IDIBAPS ha inyectado células de un paciente con leucemia linfática crónica a un ratón.
Este tipo de modelo se denomina xenoinjertos derivados de paciente, y este es el primero en el que a partir de células de un paciente con leucemia linfática crónica se consigue generar un modelo de transformación de Richter, recapitulando lo que pasa en el paciente meses después.
"Hemos visto que el modelo de ratón imita morfológica y molecularmente la leucemia del mismo paciente, llegándose a producir la transformación de Richter, lo que lo convierte en una herramienta primordial para comprender esta transformación y buscar nuevas terapias más efectivas", ha señalado Dolors Colomer, jefa del grupo de investigación del IDIBAPS, jefa de la sección de Hematopatología del servicio de Anatomía patológica del Clínic Barcelona y miembro de CIBERONC.
UN TRATAMIENTO PROMETEDOR
Los análisis moleculares, que se han realizado gracias a este nuevo modelo, han revelado que, después de desarrollar la transformación de Richter, las células del linfoma muestran una alta fosforilación oxidativa y una baja señalización del receptor de las células B, lo que explicaría la resistencia a ciertos tratamientos que desarrollan muchos pacientes.
Heribert Playà Albinyana, un investigador predoctoral en el IDIBAPS, miembro de CIBERONC y el primer autor del estudio, explica que, a raíz de estos resultados, probaron si la inhibición de la fosforilación oxidativa podría detener o frenar la evolución del linfoma. Los resultados obtenidos, tanto en las células de cultivo como en el modelo de ratón son prometedores, ya que muestra una reducción significativa en la proliferación de células tumorales.
YA HAY CÉLULAS DE LINFOMA MÁS AGRESIVAS EN LAS PRIMERAS ETAPAS
El hecho de que al inyectar células de leucemia linfática crónica en los ratones se acabe desarrollando la transformación de Richter, ya da las primeras señales de que estas células más agresivas, capaces de desarrollar un linfoma, están presentes en las etapas más tempranas de la enfermedad.
La secuenciación de las células tumorales en el nuevo modelo de ratón confirma esta sospecha. Al comienzo de la leucemia ya hay un pequeño grupo de células tumorales con las características moleculares de la transformación de Richter.
"Aparentemente, en la transformación de Richter, este pequeño grupo de células más agresivas comenzaría a proliferar para generar el nuevo linfoma", dice Ferran Nadeu, investigador postdoctoral en IDIBAPS-. "Esto confirma los resultados anteriores de nuestro grupo publicados el último año en la revista 'Nature Medicine'", ha remachado.
También te puede interesar
Lo último








